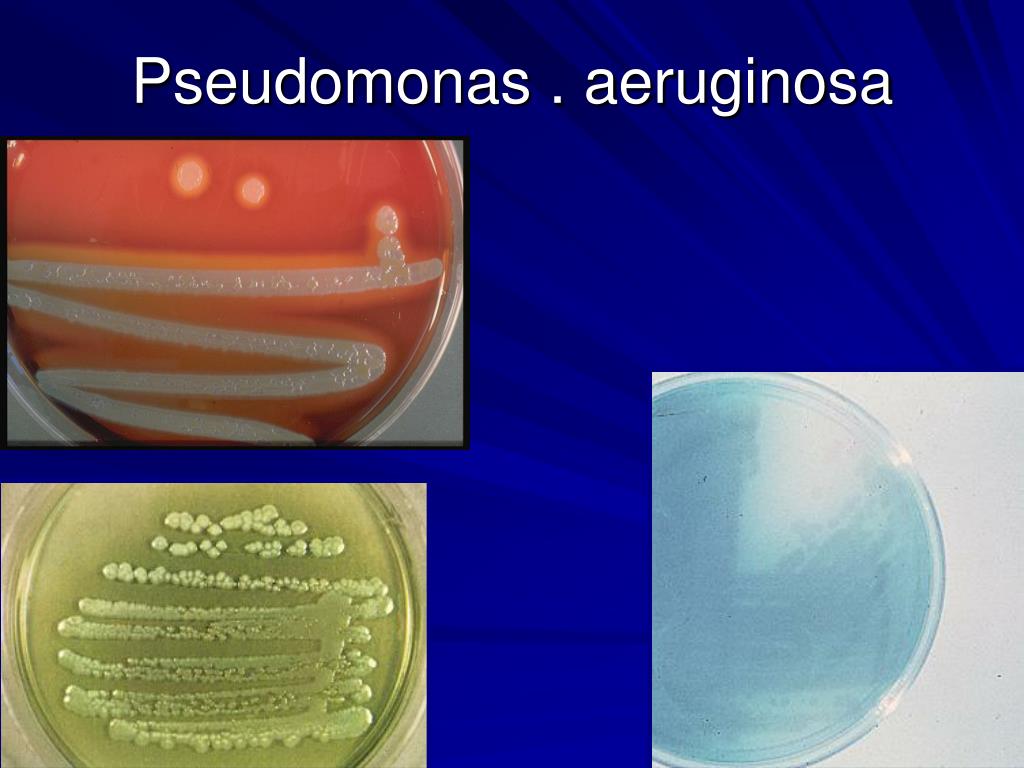
Pseudomonas Aeruginosa Strain Isolated From Different Samples

In addition to the information above, here is a curated collection of images related to Experiment1 The Preparation Of Solutions Of Chegg Com.
- Experiment1 The Preparation Of Solutions Of | Chegg.com
- Solved | Chegg.com
- Solved 1 | Chegg.com
- Solved Question | Chegg.com
- Solved Pr Chegg Study Textbook Solutions Expert Q&a Study | Chegg.com